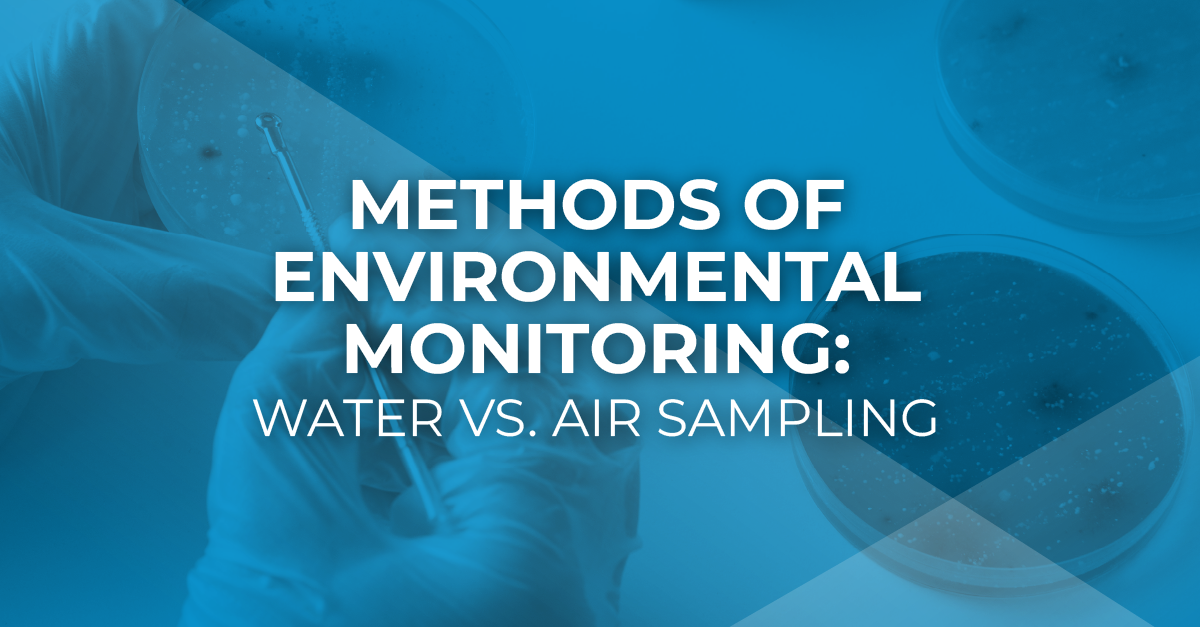
Methods of Environmental Monitoring: Water vs. Air Sampling - Millstone ...

Examine the remarkable technical aspects of types of sampling methods in environmental monitoring | gmp insiders with numerous detailed images. explaining the functional elements of flower, tree, and plant. perfect for technical documentation and manuals. Each types of sampling methods in environmental monitoring | gmp insiders image is carefully selected for superior visual impact and professional quality. Suitable for various applications including web design, social media, personal projects, and digital content creation All types of sampling methods in environmental monitoring | gmp insiders images are available in high resolution with professional-grade quality, optimized for both digital and print applications, and include comprehensive metadata for easy organization and usage. Explore the versatility of our types of sampling methods in environmental monitoring | gmp insiders collection for various creative and professional projects. Regular updates keep the types of sampling methods in environmental monitoring | gmp insiders collection current with contemporary trends and styles. Diverse style options within the types of sampling methods in environmental monitoring | gmp insiders collection suit various aesthetic preferences. Instant download capabilities enable immediate access to chosen types of sampling methods in environmental monitoring | gmp insiders images. Whether for commercial projects or personal use, our types of sampling methods in environmental monitoring | gmp insiders collection delivers consistent excellence.